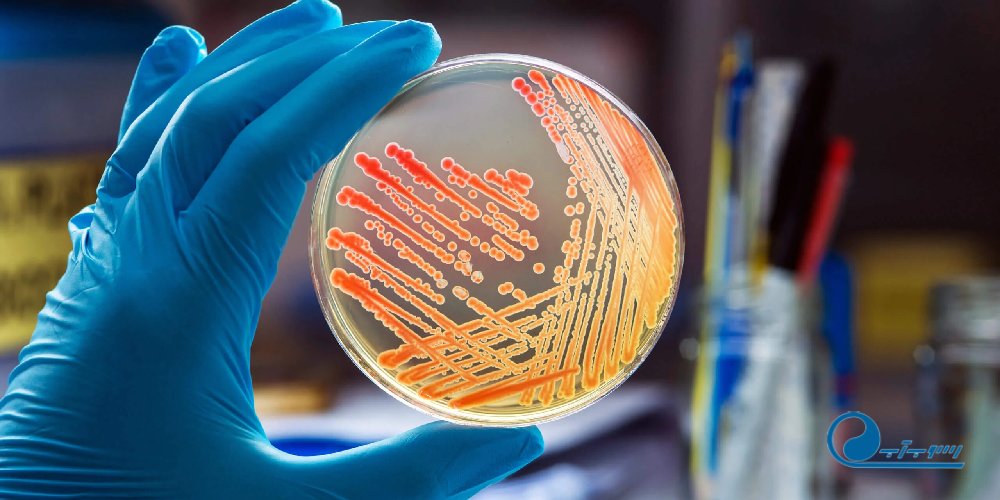
کاربرد میکروب شناسی در صنایع غذایی و بهداشتی

صنایع غذایی و بهداشتی به دلیل ارتباط مستقیم با سلامت انسانها، نیازمند رعایت دقیق استانداردهای کیفی و بهداشتی هستند. یکی از ابزارهای اساسی برای تضمین سلامت محصولات در این صنایع، علم میکروبشناسی است. میکروبها، اگرچه بسیاری از آنها عامل بیماری هستند، اما در عین حال نقش مهمی در تولید و حفظ کیفیت مواد غذایی ایفا میکنند. میکروبشناسی صنعتی به کمک آزمایشگاهها و روشهای نوین، این امکان را فراهم میآورد که محصولات سالم و استاندارد تولید شوند و از آلودگیها و فساد مواد غذایی جلوگیری شود.
نقش میکروبشناسی در کنترل کیفیت مواد غذایی
یکی از مهمترین کاربردهای میکروبشناسی در صنایع غذایی، کنترل کیفیت مواد غذایی است. با استفاده از تکنیکهای میکروبیولوژیکی، میتوان میزان آلودگی میکروبی را اندازهگیری و انواع میکروبهای موجود را شناسایی کرد. این اطلاعات به تولیدکنندگان کمک میکند تا از بروز مشکلات بهداشتی پیشگیری کنند و محصولاتی با ماندگاری بالا و ایمنی کامل به بازار عرضه کنند.
میکروبشناسی صنعتی شامل بررسی میکروارگانیسمهای مفید و مضر است. برای مثال، در فرآیند تولید ماست و پنیر، باکتریهای مفیدی مانند لاکتوباسیلوس و استرپتوکوکوسها نقش حیاتی در تخمیر دارند و طعم و کیفیت محصول را تعیین میکنند. در عین حال، باکتریهای بیماریزا مانند سالمونلا و اشریشیا کلی میتوانند سلامت مصرفکننده را تهدید کنند، بنابراین شناسایی و حذف آنها ضروری است.
جدول زیر نمونهای از میکروبهای رایج در صنایع غذایی و اثرات آنها را نشان میدهد:
| نوع میکروب | کاربرد یا اثر در صنایع غذایی | اثرات سلامتی |
|---|---|---|
| لاکتوباسیلوس | تخمیر محصولات لبنی | مفید، تقویت سیستم گوارشی |
| استرپتوکوکوس ترموفیلوس | تخمیر ماست | مفید، افزایش ماندگاری |
| سالمونلا | عامل آلودگی احتمالی | بیماریهای گوارشی، تب بالا |
| اشریشیا کلی | آلودگی مواد غذایی | اسهال، عفونتهای رودهای |
| کپکها (Aspergillus) | تولید پنیرهای خاص | برخی گونهها سمی هستند |
شناسایی میکروبها در صنایع غذایی
شناسایی دقیق میکروبها در صنایع غذایی، پایهایترین مرحله در تضمین سلامت محصولات است. روشهای سنتی شامل کشت میکروبی در محیطهای رشد مخصوص است، اما امروزه با استفاده از تکنیکهای مولکولی مانند PCR و توالییابی ژنتیکی، شناسایی سریع و دقیق میکروارگانیسمها امکانپذیر شده است.
استفاده از روشهای میکروبشناسی مدرن باعث کاهش زمان شناسایی و افزایش دقت نتایج میشود. این روشها همچنین امکان تشخیص میکروبهای غیرقابل کشت را فراهم میکنند و میتوانند به تولیدکنندگان کمک کنند تا سریعتر اقدامات اصلاحی را انجام دهند.
میکروبشناسی در صنایع بهداشتی
در صنایع بهداشتی، میکروبشناسی نقش بسیار مهمی در پیشگیری از عفونتها و تضمین سلامت محصولات ایفا میکند. محصولات بهداشتی مانند صابونها، کرمها و مواد آرایشی بهداشتی، ممکن است در طول تولید یا نگهداری با میکروب آلوده شوند. وجود میکروبهای بیماریزا میتواند باعث بروز عفونت پوستی یا مشکلات جدیتر شود.
آزمایشهای میکروبیولوژیک در این صنایع شامل اندازهگیری میزان کل میکروبها، شناسایی باکتریهای خاص و بررسی تأثیر فرآیندهای ضدعفونیکننده بر میکروبها است. این آزمایشها به تولیدکنندگان کمک میکنند تا محصولاتی ایمن و با کیفیت بالا تولید کنند و از آسیبهای مالی و بهداشتی جلوگیری شود.
کاربردهای عملی میکروبشناسی در صنایع غذایی و بهداشتی
میکروبشناسی در صنایع غذایی و بهداشتی کاربردهای متنوعی دارد که میتوان آنها را به چند دسته اصلی تقسیم کرد:
1. پیشگیری از فساد مواد غذایی
شناخت و کنترل میکروبهای مضر باعث افزایش ماندگاری مواد غذایی میشود. به کمک آزمایشگاه میتوان شرایط نگهداری، دما و رطوبت مناسب برای جلوگیری از رشد میکروبها را تعیین کرد و بستهبندیهای بهینه را طراحی نمود.
2. تضمین ایمنی محصولات
شناسایی میکروبهای بیماریزا و حذف آنها از محصولات، سلامت مصرفکننده را تضمین میکند. این فرآیند شامل آزمایش نمونهها در مراحل مختلف تولید و پس از بستهبندی است.
3. بهبود کیفیت محصولات تخمیری
فرآیندهای تخمیری در صنایع غذایی مانند تولید ماست، پنیر و نوشیدنیهای پروبیوتیک به حضور میکروبهای مفید نیاز دارند. کنترل دقیق این میکروبها با کمک میکروبشناسی باعث بهبود طعم، عطر و ارزش غذایی محصولات میشود.
4. ارزیابی اثر فرآیندهای ضدعفونیکننده
در صنایع بهداشتی و غذایی، فرآیندهای ضدعفونیکننده باید اثربخش باشند. آزمایشگاههای میکروبشناسی میتوانند با شبیهسازی شرایط واقعی، اثر مواد ضدعفونیکننده را ارزیابی کنند و به تولیدکننده در بهینهسازی فرآیند کمک کنند.
تکنولوژیهای نوین در میکروبشناسی صنعتی
با پیشرفت فناوری، ابزارها و روشهای نوین میکروبشناسی امکان شناسایی سریع و دقیق میکروبها را فراهم کردهاند. از جمله این روشها میتوان به استفاده از سیستمهای خودکار شمارش کلنی، PCR و میکروآرایهها اشاره کرد.
این تکنولوژیها باعث افزایش سرعت تحلیل، کاهش خطاهای انسانی و ارائه دادههای دقیق برای تصمیمگیریهای مدیریتی میشوند. همچنین، استفاده از این روشها در صنایع غذایی و بهداشتی باعث بهبود فرآیند کنترل کیفیت و تضمین سلامت محصولات میشود.
نمونههای کاربردی در صنایع مختلف
در ادامه به نمونههای کاربردی در صنایع مختلف اشاره میکنیم:
صنایع لبنی
در تولید شیر، ماست و پنیر، شناسایی و کنترل میکروبهای مفید و مضر ضروری است. آزمایشگاه میتواند با بررسی نمونهها در مراحل مختلف تولید، رشد باکتریهای مفید و جلوگیری از آلودگی میکروبی را تضمین کند.
صنایع نوشیدنی
در تولید نوشابهها و آبمیوهها، جلوگیری از رشد میکروبهای مضر مانند باکتریها و کپکها اهمیت ویژهای دارد. میکروبشناسی کمک میکند تا شرایط بستهبندی و نگهداری بهینه برای افزایش ماندگاری و حفظ طعم محصول فراهم شود.
صنایع آرایشی و بهداشتی
محصولات آرایشی و بهداشتی، به دلیل تماس مستقیم با پوست، نیازمند کنترل دقیق میکروبی هستند. آزمایشهای میکروبیولوژیک در این حوزه به شناسایی آلودگیهای احتمالی، بررسی اثر مواد نگهدارنده و تضمین ایمنی محصول کمک میکنند.
جدول مقایسه روشهای سنتی و مدرن میکروبشناسی
| روش | مزایا | معایب |
|---|---|---|
| کشت میکروبی سنتی | هزینه پایین، آسان برای انجام | زمانبر، عدم شناسایی میکروبهای غیرقابل کشت |
| PCR و روشهای مولکولی | سرعت بالا، دقت بالا | نیاز به تجهیزات پیشرفته و هزینه بالاتر |
| میکروآرایهها و سنسورها | شناسایی همزمان چندین میکروب | پیچیدگی تحلیل دادهها، نیاز به تخصص بالا |
اهمیت آموزش و تخصص در میکروبشناسی صنعتی
موفقیت در کاربرد میکروبشناسی در صنایع غذایی و بهداشتی، علاوه بر تجهیزات پیشرفته، نیازمند تخصص و مهارت کارشناسان آزمایشگاه است. دانش علمی در زمینه میکروبشناسی، شناخت دقیق محیطهای رشد میکروبی، تجربه در شناسایی و ارزیابی نمونهها و توانایی استفاده از تکنولوژیهای نوین، همگی از عوامل موفقیت آزمایشگاهها در تضمین کیفیت و ایمنی محصولات هستند.
نتیجهگیری
میکروبشناسی صنعتی ابزار کلیدی در کنترل کیفیت، تضمین ایمنی و بهبود فرآیندهای تولید در صنایع غذایی و بهداشتی است. شناسایی دقیق میکروبها، کنترل رشد آنها و استفاده از تکنیکهای نوین میکروبشناسی، نقش حیاتی در تولید محصولات سالم و با کیفیت دارد. با توجه به افزایش آگاهی مصرفکنندگان و نیاز به محصولات ایمن، سرمایهگذاری در آزمایشگاههای مجهز و آموزش کارشناسان حرفهای از اهمیت ویژهای برخوردار است.
برای انجام خدمات آزمایشگاهی در زمینه میکروبشناسی صنعتی، میتوانید با شرکت رسوب آب تماس بگیرید. این شرکت با تجهیزات پیشرفته و تیم قوی از کارشناسان، خدماتی کامل و دقیق در زمینه آزمایشات میکروبی ارائه میکند. کارشناسان رسوب آب با دانش علمی بهروز و تجربه عملی، کیفیت محصولات شما را تضمین میکنند و به شما کمک میکنند تا ایمنی و ماندگاری محصولات غذایی و بهداشتی خود را به حداکثر برسانید. این خدمات به شما امکان میدهد با اطمینان کامل، محصولات خود را به بازار عرضه کنید.